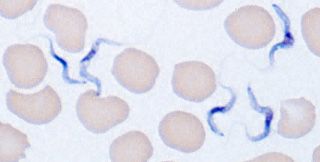
T. b. rhodesiense, Giemsa stain
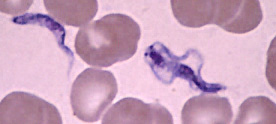
Dividing T. b. rhodesiense

|
Microscopy
 |
 |
| A |
B |
A, B: Two
areas from a blood smear from a patient with African trypanosomiasis. Thin blood
smear stained with Giemsa. Typical trypomastigote stages (the only stages found in
patients), with a posterior kinetoplast, a centrally located nucleus, an undulating
membrane, and an anterior flagellum. The two T. brucei species that cause
human trypanosomiasis, T. b. gambiense and T. b. rhodesiense, are
indistinguishable morphologically. The trypanosomes length range is 14
to 33 µm.
 |
| C |
 |
| D |
C, D: Blood smear from a patient
with T. b. rhodesiense, Giemsa stain. D shows the
same field as C, with the addition of differential interference contrast (DIC) which
better visualizes the flagella (DIC is not necessary for diagnosis!). 41-year-old man who had
returned from a trip to Tanzania. Specimen contributed by Dr. Phil
Smith, Omaha, Nebraska.
 |
| E |
E: Blood
smear from a patient (a U.S. traveler) with T. b. rhodesiense. A dividing
parasite is seen at the right. Dividing forms are seen in African trypanosomiasis,
but not in American trypanosomiasis (Chagas disease).
 |
| F |
F: Blood
smear from a patient with T. b. gambiense. Image contributed by Prof. J.
Le Bras, Hôpital Bichat - Claude Bernard, Paris, France.
|
|